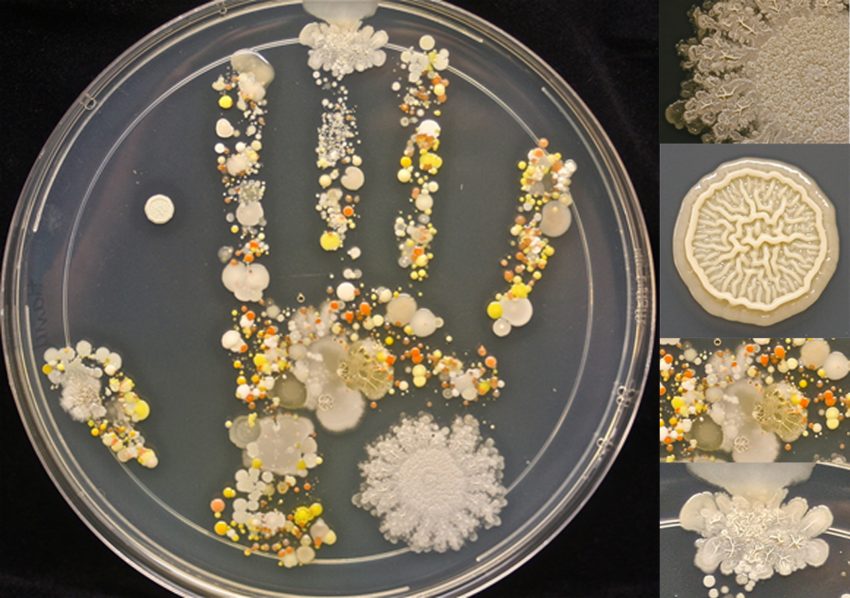
poza articol

- Eficienţă în dezinfecţie!
- 0232315433
- 0374490115
- office@biocomp.ro
Blog
Importanta microorganismelor în viitorul umanitatii si al planetei este de necontestat, dar prea putine persoane înteleg acest lucru, mai ales cand „interesul pentru microbiologie este lasat în întuneric, abandonandu-l doar catorva experti”sustine, directorul Micropia. Universul microscopic într-un singur loc? O lume in care omul interactioneaza direct cu microbii? De ce nu? Va propunem un mic salt în trecut… si ne aflam în Amsterdam, într-o zi de marti, prin anul 2014, cand un […]
Primaria Municipiului Iasi invita cetatenii, comunitatile si mediul de afaceri iesean sa contribuie la dezvoltarea urbana integrata a orasului, prin dezbateri publice si propuneri de idei si proiecte. Societatea comerciala BIOCOMP raspunde cu drag acestei invitatii si este pregatita sa sustina, in special, capitolul performantei in domeniul Sanatatii, prin oferirea de alternative non-chimice si non-chirurgicale impotriva infectiilor nosocomiale si a celor asociate asistentei medicale din spitale si alte cabinete medicale specializate publice […]
Chiar daca suntem specializati sa identificam fiecare microorganism care ar putea sa ne puna sanatatea in pericol, mereu ne bucuram cand aflam ca exista si anumite bacterii pozitive care nu ne dauneaza, ba chiar ne ajuta sa simtim anumite momente, intr-un mod cu totul special.. Hmm, mirosul pamantului ud dupa o ploaie de primavara..o mireasma unica si puternica de prospetime si viata, pe care o inhalam cu pofta, pana in adancul plamanilor. […]
Ne-am intors bucurosi, energizati si plini de entuziasm de la Expo-Conferinta Internationala Meat&Milk, Editia a V-a, organizata la Poiana Brasov! Ne-am bucurat sa cunoastem oameni noi, sa prezentam produsele noastre si sa vorbim in cadrul conferintei generale despre importanta sigurantei produselor alimentare si a protectiei populatiei. Biocomp a promovat produsele si serviciile sale care dezinfecteaza si distrug microorganismele daunatoare in aer si suprafetele de lucru. Iata cateva fotografii de la eveniment: […]
Laptele crud si colostrul pot adaposti microorganisme periculoase care prezinta riscuri grave la adresa sanatatii animalelor si oamenilor. În conformitate cu USDA, mai mult de 58% dintre viteii din Statele Unite sunt hraniti cu lapte nepasteurizat. Scopul acestui studiu a fost acela de a evalua efectul luminii UV asupra reducerii bacteriilor din lapte si colostru, si pe IgG colostru. O lumina UV pilot la scara continua (UV-C) cu unitate de scurgere -45 […]
Saptamana viitoare, BIOCOMP participa ca expozant si speaker in cadrul Expo-Conferinta Internationala Meat&Milk, editia a V-a, 12-13 mai, Poiana Brasov! Dorim să iti oferim cel mai bune solutii pentru o dezinfectie sigura, si de aceea participam cu bucurie in cadrul acestui eveniment punctand tema: “Standardele de igiena si siguranta produselor… vorbim de fapt despre oameni si vietile lor!” Te asteptam alaturi de noi, la conferinta si apoi in zona Expo unde BIOCOMP va avea propriul stand […]
Ingrijorarea pentru sanatatea dvs reprezinta esenta produselor Biocomp- lampi bactericide LBA create pentru dezinfectie si sterilizare impotriva microorganismelor daunatoare. Detinem certificatul Dekra pentru sistemul de management al calitatii, prin standardul ISO 9001:2008, care ne permite sa aducem plus valoare produselor si serviciilor noastre. Biocomp este liderul pe piata romana, cu o experienta de 25 de ani si mii de clienti satisfacuti. In domeniile in care activam, respectiv medical, veterinar, alimentar, cosmetic, educational […]
În lumea de astazi suntem înconjurati de o avalansa de marci comerciale. Acestea contribuie la bunastarea si fericirea noastra de zi cu zi, ajutându-ne sa facem diferentierea dintre produse. Marcile comerciale ne ajuta sa decidem care produse ni se potrivesc cel mai bine, în orice context al vietii noastre. Fie că este vorba de marca de apă minerală pe care o consumăm pe moment, marca telefonului preferat, brandul pe care îl selectăm […]
Sanatatea si imbunatatirea standardului de viata reprezinta filosofia Biocomp si credem ca protectia si siguranta umana sunt elemente primordiale ale unei vieti frumoase. Din acest motiv ne documentam temeinic si va oferim informații specializate din domeniul medical sau altele adiacente. Astfel, va povestim astazi de Doamna Tasha Sturm, mamica unui baietel de 8 ani, tehnician al Laboratorului de Microbiologie la Cabrillo College din California, USA, care a efectuat un test-experiment prin care […]
Biocomp este în permanena la curent cu cele mai noi informatii din domeniile în care activeaza, respectiv medical, alimentar, veterinar, cosmetic, educational si casnic. În fiecare dintre acestea, mentinerea sanatatii este primordiala, motiv pentru care Biocomp va recomanda Lampile Bactericide recunoscute pentru calitatea si eficienta lor în dezinfectie de-a lungul a 25 de ani de existenta pe piata. Astăzi, dorim să sărbătorim împreună cu dvs. Ziua Mondială a Sănătății prin care se consacră […]